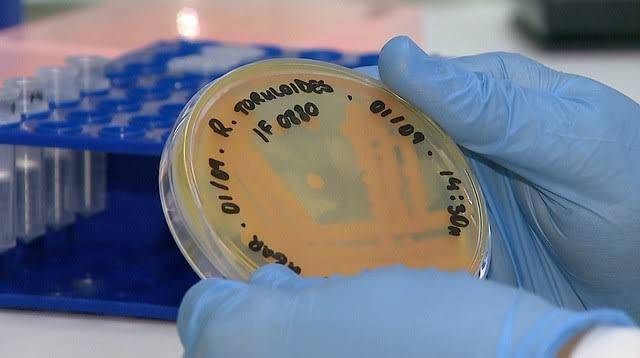

Estar sempre atualizado nГЈo Г© uma tarefa simples para o mГ©dico. Os congressos mГ©dicos sГЈo encontros importantes para ficar em dia com as novidades da ГЎrea, alГ©m de trocar experiГЄncias ...
Os integrantes da ComissГЈo Parlamentar de InquГ©rito (CPI), instaurada na CГўmara Municipal de CuiabГЎ para apurar os repasses de recursos pГєblicos à Santa Casa de MisericГіrdia, ...
A Folha de S. Paulo publicou em sua edição deste sábado (5) artigo assinado pelo presidente do Conselho Federal de Medicina (CFM), Mauro Ribeiro, e pelo desembargador do Tribunal de ...
O presidente Jair Bolsonaro defendeu nesta sexta-feira (4) que a Medida ProvisГіria 890/2019, que cria o Programa MГ©dicos pelo Brasil, seja mantida em seu formato original pelo Congresso. ...
Com a chegada de mais um Dia do Médico, a PEBMED preparou uma programação especial totalmente online, grátis e muito relevante para apoiar os médicos na era digital e na prática ...
Um estudo mapeou as comunidades de microrganismos que habitam as unidades de tratamento intensivo (UTIs). O local mapeado pelos pesquisadores foi o Hospital das ClГnicas da Faculdade ...
Presidente da gestГЈo 2014-2019 do Conselho Federal de Medicina (CFM), Carlos Vital abriu a solenidade de posse dos novos membros da autarquia, realizada em BrasГlia na noite de 1º ...
Há muita desinformação nas redes sociais sobre a medida provisória do Médicos Pelo Brasil (MPV 890/2019). É claro o objetivo de confundir a população e desviar o foco sobre os ...
O Conselho Federal de Medicina (CFM) divulgou, nesta quarta-feira (2), uma sГ©rie de esclarecimentos, em formato de perguntas e respostas, sobre a Resolução nº 2.232/19, ...